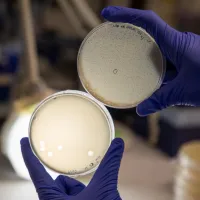
Two petri dishes held up by gloved hands, showing bacterial lysis by phages.

Research institutes, centres and groups
-

Antibody Drug Development
Our interdisciplinary research generates antibody-based therapeutics for cancer and autoimmunity. -

Biomedical Imaging Unit
We provide research and diagnostic services in high quality, high-resolution light and electron microscopy, specialising in 3D imaging. -

Cancer B-Cell Group
Our research translates new understanding of tumour B-cell biology into clinical practice. -

Centre for Democratic Futures
We carry out interdisciplinary research on the conditions of achieving democratic futures, ranging from conceptual debates to challenges of institutional innovation and public policy. -

Institute for Life Sciences
We bring together interdisciplinary researchers with expertise across the themes of health and medicine, living systems, disruptive life technologies, and insights through data -

Institute of Developmental Sciences
Researching collaboratively to advance health across the life course through research and innovation in the developmental sciences -
Microbiology
We bring together cross‑disciplinary expertise to uncover microbial mechanisms, innovate new interventions, and translate fundamental discoveries into impactful applications across health, agriculture, and the environment. -

National Biofilms Innovation Centre (NBIC)
NBIC is the central hub where academia, industry, government and public policy come together to tackle the grand challenges biofilms present, impacting $4 trillion in global economic activity. -

Precision Biosciences Innovation Hub
We use big data, computational approaches and 'in silico' digital twins of biological systems. Through our research, we gain a detailed understanding of the biological processes needed for sustainable health, environment and food. -

Southampton Marine and Maritime Institute
We work with partner organisations to tackle global marine and maritime challenges, from developing green technologies to influencing government policy.










